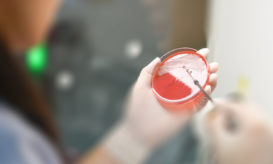

Νέα επικίνδυνο ανθεκτικό μικρόβιο βρέθηκε στα ελληνικά νοσοκομεία – Καμπανάκι από το ECDC
Τι ανακάλυψαν οι επιστήμονες αναλύοντας δείγματα του 2019 από 323 νοσοκομεία σε 36 ευρωπαϊκές χώρες.

Τι ανακάλυψαν οι επιστήμονες αναλύοντας δείγματα του 2019 από 323 νοσοκομεία σε 36 ευρωπαϊκές χώρες.

Απρόσμενα ευρήματα νέας μελέτης. Η ανθεκτικότητα έφθανε στο 76% στα μωρά. Πώς μολύνθηκαν.

Αυξάνονται και οι θάνατοι από λοιμώξεις ανθεκτικές στα αντιβιοτικά έσχατης ανάγκης για την αντιμετώπισή τους.

Στην Ελλάδα υπάρχουν βακτήρια τα οποία έχουν ανθεκτικότητα πάνω από 78% σε σημαντικά αντιβιοτικά.

Θανάσιμος κίνδυνος από την κατάχρηση των πιο αποτελεσματικών αντιβιοτικών. Τι αποκαλύπτει νέα μελέτη.

Τι συνέβη το 2015 με τους νέους που υπέστησαν σοβαρά εγκαύματα σε πυρκαγιά σε κλαμπ της Ρουμανίας.

Τι αναφέρουν οι δύο κορυφαίοι ευρωπαϊκοί οργανισμοί σε νέα έκθεσή τους. Ποια μικρόβια απειλούν την υγεία μας.

Ποιοι είναι οι βασικοί κανόνες για να τα χρησιμοποιούμε σωστά, σύμφωνα με τους ειδικούς. Τι αναφέρει ο ΕΟΔΥ.

Ποιους απειλούν περισσότερα τα βακτήρια που είναι ανθεκτικά στα αντιβιοτικά. Τα μέτρα προστασίας.

Ειδικοί από τις ΗΠΑ εξηγούν ποια είναι τα λάθη που κάνουμε με τη χρήση αντιβιοτικών φαρμάκων.
Δυσοίωνες προβλέψεις από το ευρωπαϊκό ΚΕΕΛΠΝΟ, καθώς αυξάνονται ραγδαία οι λοιμώξεις από ανθεκτικά μικρόβια.

Η όλη έρευνα βρίσκεται σε αρχικά στάδια, αλλά δημιουργεί ελπίδες για την ανάπτυξη νέων αντιμικροβιακών θεραπειών.

Τα ευρήματα νέας έρευνας σε μελέτη με σχεδόν 2.900 ασθενείς και τα κατοικίδιά τους (σκύλους ή/και γάτες).

Η Ελλάδα και η Ιταλία είναι οι δύο χώρες του ΟΟΣΑ όπου το πρόβλημα της ανθεκτικότητας των μικροβίων στα...

"Ζητήστε συμβουλές από ειδικευμένο επαγγελματία υγείας πριν πάρετε αντιβιοτικά" είναι το φετινό μήνυμα της Παγκόσμια Ημέρας κατά των Αντιβιοτικών,...